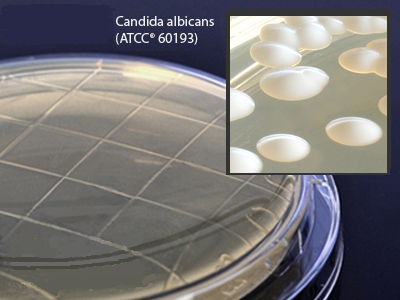

Product Information
Certificate of Analysis
Sabdex (Sabouraud Dextrose) Agar, contact plate with friction lid, for surface testing, order by the package of 10
Sabouraud Dextrose Agar is recommended for the selective isolation of fungi and yeasts from environmental, clinical, and nonclinical specimens.